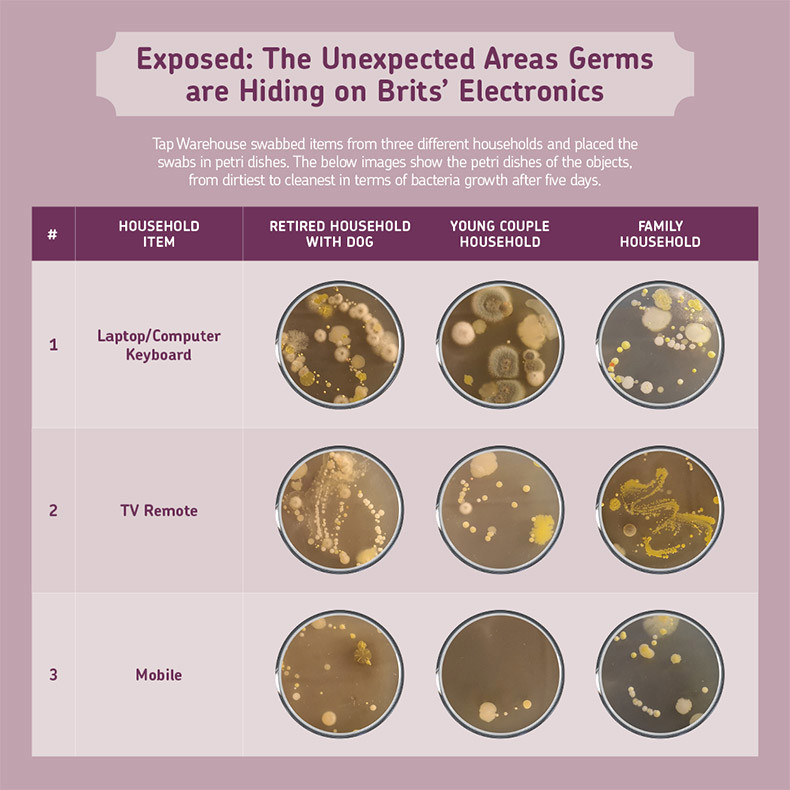
grems-on-british-electronics
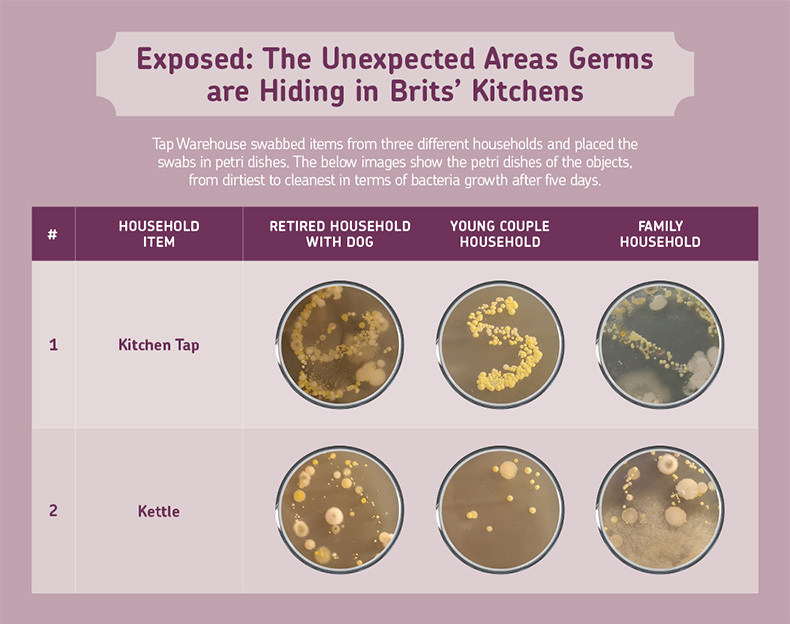
germs-in-british-kitchens

Brits are cleaning more than ever before since lockdown. In fact, the average Brit now spends an extra 63 minutes each week cleaning. But, does this cleaning really go deep enough? It turns out that there may still be germs lurking in unexpected places…
To uncover which everyday items are the filthiest, we swabbed 30 items in total from three different households. This included a selection from the kitchen, bathroom as well as electronic, family and dog items.
After five days of bacterial growth, we then enlisted the expertise of Dr Amanda Jones at Northumbria University to expose the nasty germs on these everyday items. We then spoke to cleaning expert, Henry Paterson, from Housekeep to explain how to thoroughly clean these items.
Experts Explain: How Important is it to Clean our Homes Regularly?
Evidently, Brits are experiencing a cleaning boom, with 57% of Brits confessing to cleaning more now since lockdown. But, is it really that essential to clean so much?
Well, apparently, we can never be too clean. Henry Paterson, Senior Operations Executive at Housekeep says that “everyday household items often harbour a whole host of germs, including E. coli, cold viruses, the flu virus and even coronavirus (COVID-19).”
He adds that while survival rates for these differ, “many of these germs can survive for hours or days on surfaces outside of the body. It’s thought that touching contaminated surfaces and then touching your nose or mouth (and possibly your eyes) could cause illness.”
So, it’s especially important to clean household items at least once a week. However, objects that are used by multiple members of the household “should be cleaned more often, particularly if people are frequently coming in and out of the home” Paterson confirms.
He adds that these items “can lead to the transmission of illness between family members and housemates. Similarly, children’s toys are often used by groups of friends and siblings, so could be a vehicle for illness to spread.”
So, now that’s cleared up, let’s find out which areas we should be paying particular attention to...
Computer Virus: The Laptop is the Dirtiest Electronic in the Home
When you think about germ-riddled areas in your home, the kitchen or bathroom probably comes to mind. However, our research revealed the dirtiest item is in fact your laptop/ computer keyboard.
Delving more into the demographics, it was the younger couple that were working from home who had the grimiest laptop. However, this should come as no surprise when you consider the average office worker spends six and a half hours in front of a computer screen, which amounts to a staggering 1,700 hours over the period of a year.
Even when working from home, Brits should be making a conscious effort to clean their computers - otherwise they could be putting themselves at risk of an infection. Dr Amanda Jones, Associate Professor in Microbiology at Northumbria University, says the most likely germs hiding on your laptop are “staphylococci, streptococci and some airborne bacteria such as micrococci.” These can lead to skin infections and pharyngitis.
Further research has also shown that computer keyboards are the most contaminated with bacilli, which is a bacteria that can cause meningitis and food poisoning.
Not Even Remotely Clean: The TV Remote is the 2nd Germiest Electronic Item
The TV remote is touched daily and, sometimes not just by one hand, but several. Some people may even eat in front of the TV, giving themselves extra sticky hands. With this in mind, think back to the last time you cleaned your remote...
Apparently not in a while, or even once, as our study has discovered that the remote is the 2nd dirtiest electronic item. This seemingly innocent object could be, in fact, laden with “staphylococci and streptococci” just like the laptop, says Dr Amanda Jones.
How to Clean Your Electronics According to a Cleaning Expert
But, what’s the best way to keep germs at bay without damaging your electronics?
Henry Paterson, Senior Operations Executive at house cleaning service, Housekeep, advises, “To clean electronics, such as TV remotes or computer keyboards, you should use alcohol wipes or a small quantity of rubbing alcohol (isopropyl alcohol) applied to a microfibre cloth. Alcohol evaporates quickly, and doesn't leave behind excess moisture which could damage electronics. Choose a product with 60-80% concentration for optimum effect, as higher concentrations can evaporate before they've had sufficient contact time to sanitise.”

Are You Washing Your Hands with Poo?
The damp and humid conditions of a bathroom are a perfect breeding ground for bacteria. What’s more, the bathroom tap is often the first thing people touch after they go to the toilet.
So, it’s little surprise that the tap is the grimest item in the bathroom and can contain “escherichia coli (e. coli) and other faecal types of bacteria”, admits Dr Amanda Jones.
Not only that, but studies have shown bathroom taps to be loaded with yeast and mould. Therefore, each time you go to wash your hands, you could be washing them with poo and mould.
How to Clean Your Bathroom Tap According to an Expert
If you’re wondering what is the best way to clean your taps, just follow these three steps:
- It’s best to avoid abrasive cleaners that contain bleach as this could ruin your taps. Instead, use warm soapy water and rub the tap with a soft cloth.
- To remove limescale, soak cotton wool or a cloth in white vinegar then place on areas with limescale. You may need to leave it overnight depending on how tough the limescale is.
- You can keep on top of water marks and limescale by wiping your taps daily with water and a cloth. Although, you will still need to do a thorough clean every week to remove germs.
Is Your Kitchen Tap Putting You at Risk of Food Poisoning?
Many areas come to mind when you think about dirt in the kitchen, such as worktops and chopping boards. But, have you ever wondered how filthy your kitchen tap is? This item could indeed be the dirtiest in your kitchen, with our analysis uncovering it had the most bacteria growth.
Dr Amanda Jones from Northumbria University adds “the kitchen tap would have the same skin bacteria and also food contaminants from raw food such as bacillus species and Escherichia coli (e. coli).” Bacillus and e. coli both can cause food poisoning hence why it’s so important to clean the kitchen sink and taps regularly with soap and water.
Spilling the Tea on Germs: The Kettle Could Be Giving You an Infection
There’s no doubt that Brits love tea. In fact, the average Brit drinks 876 cups of tea a year. However, despite how much we love drinking tea, we certainly don’t share the same love for cleaning the kettle. We often forget to clean this item, in spite of us touching it daily, and even more so during lockdown.
But, how dirty can a kettle even be? Well, our research has revealed that the kettle showed huge bacteria growth which could be putting Brits at risk of a skin or pharyngitis infection. As Dr Amanda Jones admitted that the kettle can harbour “staphylococci and streptococci” bacteria.
Unexpectedly, the kettle was discovered to be the germiest in the family home, beating the young couple despite them working from home. This goes to show how tired British parents are in desperate need of caffeine.
But, before you panic about your grimy kettle, it’s simple enough to keep it clean. Henry Paterson, from Housekeep states “cleaning with soap and water is often enough to remove germs.” Just remember to do this every week and avoid getting water near the electrical parts.

Mucky Pups: The Household with a Dog and the Family Home are Equally Dirty
Is your child as dirty as a dog? Apparently so. When analysing the amount of bacteria growth from the everyday household items, the home with a dog and the family home were both equally dirty.
But, what’s even more surprising is when we examine the germ swabs for the dog and child objects. The child items show massive bacteria growth that’s comparable to the dog objects. These sets of items are significantly dirtier than the everyday household objects analysed.
Not Cleaning Your Children’s Toys Can Result in Them Carrying Nasty Viruses
However, when analysing bacteria growth, the child’s item that is the dirtiest is the toy. Shockingly, researchers from Georgia State University found that viruses can survive on a plastic children’s toy for 24 hours. Richard Bearden, lead author of the study says, “People don’t really think about getting viruses from inanimate objects.” However, children are at increased risk of contracting an infection because “they put their hands and foreign objects in their mouths” adds Bearden.
How to Keep Children’s Toys Germ-Free
Most toys should be cleaned weekly if your child plays with them daily, but if they’re sick, it’s best to clean them regularly until they’ve recovered. So, what’s the best way to clean your toys?
- Plastic toys without batteries can be placed in your dishwasher or let them soak in hot soapy water, then rub clean, rinse, and leave to dry.
- Soft toys can be machine washed if they’re suitable. But, those that are non-machine washable can be spot cleaned.
- Electronic toys can be surfaced cleaned with a disinfectant.
Dirty Dog (Bed): Not Cleaning it Regularly Can Result in Ringworm for Both Pet and Owner
Did you know that dogs can carry ringworm and viruses on their fur? Not to mention that dogs are likely to walk on dirty ground outside. This means that whatever they touch afterwards,such as their bed, is a breeding ground for germs.
However, despite how necessary it is to clean a dog bed, it appears it’s often forgotten. Our research uncovered the dog bed is the filthiest dog item of the three, as well as the germiest item in the dog household altogether.
How to Clean Your Dog’s Bed According to a Cleaning Expert
With this in mind, Henry Paterson, from Housekeep, advises that “you should wash your dog bed at least once a week, or sooner if it gets soiled. Dog beds can harbour lots of germs, including MRSA and ringworm, which could be passed onto owners or other pets. To avoid irritation, use a pet-friendly laundry detergent and machine-wash at the highest recommended temperature - the tag on your dog bed should provide some more info on this. You should wash the entire bed if possible but, depending on the size, you may only be able to wash a removable cover.”
Evidently, it’s important to clean our home to keep germs at bay, however, it’s just as essential to clean our hands. Paterson says “you should make sure that you’re washing your hands as soon as you enter your home, before turning on the TV or popping the kettle on, to ensure that you’re not depositing outside germs on your household items.”
If you have enjoyed reading about the dirtiest spots in the home, perhaps you’ll like discovering the un-hygienic habits of gym-goers?
Methodology
Tap Warehouse used labelled nutrient agar in petri dishes and sterile cotton buds to swab 10 household items in three different homes. To give a fair representation, each household was from a different demographic, these included; a young couple working from home, family home with a child, and retired couple with a dog.
Hands were cleaned, and new gloves were applied in between each swab. The petri dishes were sealed after swabbing to avoid cross-contamination.
The petri dishes were stored at room temperature and recorded after five days of bacteria growth, which is the recommended length of time.